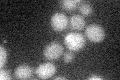
YNL291C
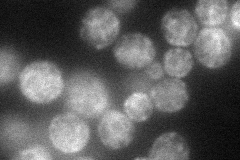
YNL291C
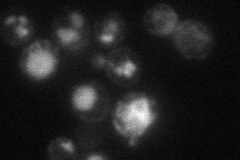
YNL291C
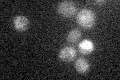
YNL291C

View description
N-glycosylated integral membrane protein of the ER membrane and plasma membrane, functions as a stretch-activated Ca2+-permeable cation channel required for Ca2+ influx stimulated by pheromone; interacts with Cch1p; forms an oligomer
Localization:
Intensity:
Fold change:
Significance:
-
C’ GFP library in SD
below threshold15.48 -
N' NOP1pr-GFP in SD
ER,punctate59.0454 -
N' TEF2pr-mCherry in SD
cell periphery,vacuole24.7766 -
N' NATIVEpr-GFP in SD

below threshold15.7703 -
N' TEF2pr-VC and Cyto-VN in SD

#N/A0 -
C’ GFP library in SD+DTT

cytosol14.110.91No -
C’ GFP library in SD+H2O2

cytosol15.420.99No -
C’ GFP library in Starvation Media
cytosol16.641.07No -
C’ GFP library on the background of Pup2-DaMP

below threshold -
C’ GFP library on the background of CCT mutant

below threshold13.96210.901622No
